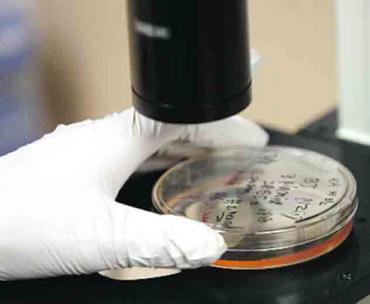

قيود أميركية على بحوث الخلايا الجذعية
المبادئ الجديدة تحظر التمويل للأجنة المستنسخة. غيتي
نشرت معاهد الصحة الوطنية الأميركية، أول من أمس، مبادئ توجيهية جديدة بشأن التمويل الاتحادي لبحوث الخلايا الجذعية، تقصره على الأجنة المتبقية في عيادات التخصيب، وتحظر التمويل للأجنة المستنسخة أو المنتجة بوسائل أخرى.
وقال القائم بعمل مدير معاهد الصحة الوطنية الأميركية، رينارد كينغتون، «من المرجح أن نزيد بشكل كبير عدد الخلايا الجذعية الجنينية البشرية المتاحة للتمويل الاتحادي». وأضاف «هذا تطور ملحوظ، ينبئ بإسراع البحث الذي ربما يؤدي ذات يوم إلى تغيير جوهري في الطريقة التي نجري بها الأبحاث الطبية». وتابع «ليس هناك شك في أن هذه المبادئ التوجيهية ستوسع بشكل كبير المجال العلمي». وتفرض المبادئ الجديدة قيوداً على تمويل العمل في الخلايا التي جرى تخليقها باستخدام طرق تجريبية بدرجة أكبر، مثل تخليق خلايا جذعية من بويضة بشرية فقط، وهي عملية تسمى التوالد العذري بالإضافة إلى تقنية استنساخ، تسمى النقل النووي لخلية جسدية.
وتحظر المبادئ أيضاً تمويل العمل بشأن أجنة جرى تخليقها للأغراض العلمية بصورة خاصة، بهدف الحفاظ على توجيه الأموال للعمل الذي يستخدم خلايا أخذت من أجنة تبرع بها الوالدان، بعد أن قررا عدم محاولة استخدام أجنة عيادات التخصيب لإحداث الحمل.
وتحدد المبادئ إرشادات للتأكد من أن الوالدين يعرفان ويوافقان على الكيفية التي ستستخدم بها الأجنة، كما تحد من استخدام أموال الضرائب الاتحادية لإنتاج نماذج إنسانية حيوانية مهجنة.
![]() تابعوا آخر أخبارنا المحلية والرياضية وآخر المستجدات السياسية والإقتصادية عبر Google news
تابعوا آخر أخبارنا المحلية والرياضية وآخر المستجدات السياسية والإقتصادية عبر Google news



